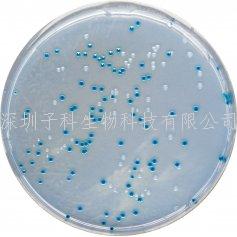

热门关键词: ELISA试剂盒 - 大鼠ELISA试剂盒- 小鼠ELISA试剂盒
全国统一客服热线:
0755-28715175
热门关键词: ELISA试剂盒 - 大鼠ELISA试剂盒- 小鼠ELISA试剂盒
全国统一客服热线:
0755-28715175

科马嘉B族链球菌显色培养基
用途:用于B群链球菌的分离和鉴别
规格和货号:
1L....................... SB282-1
5L....................... SB282
详细产品价格和货期请咨询深圳子科生物在线客服。
0755-28715175/33164177

粤公网安备 44030902000304号